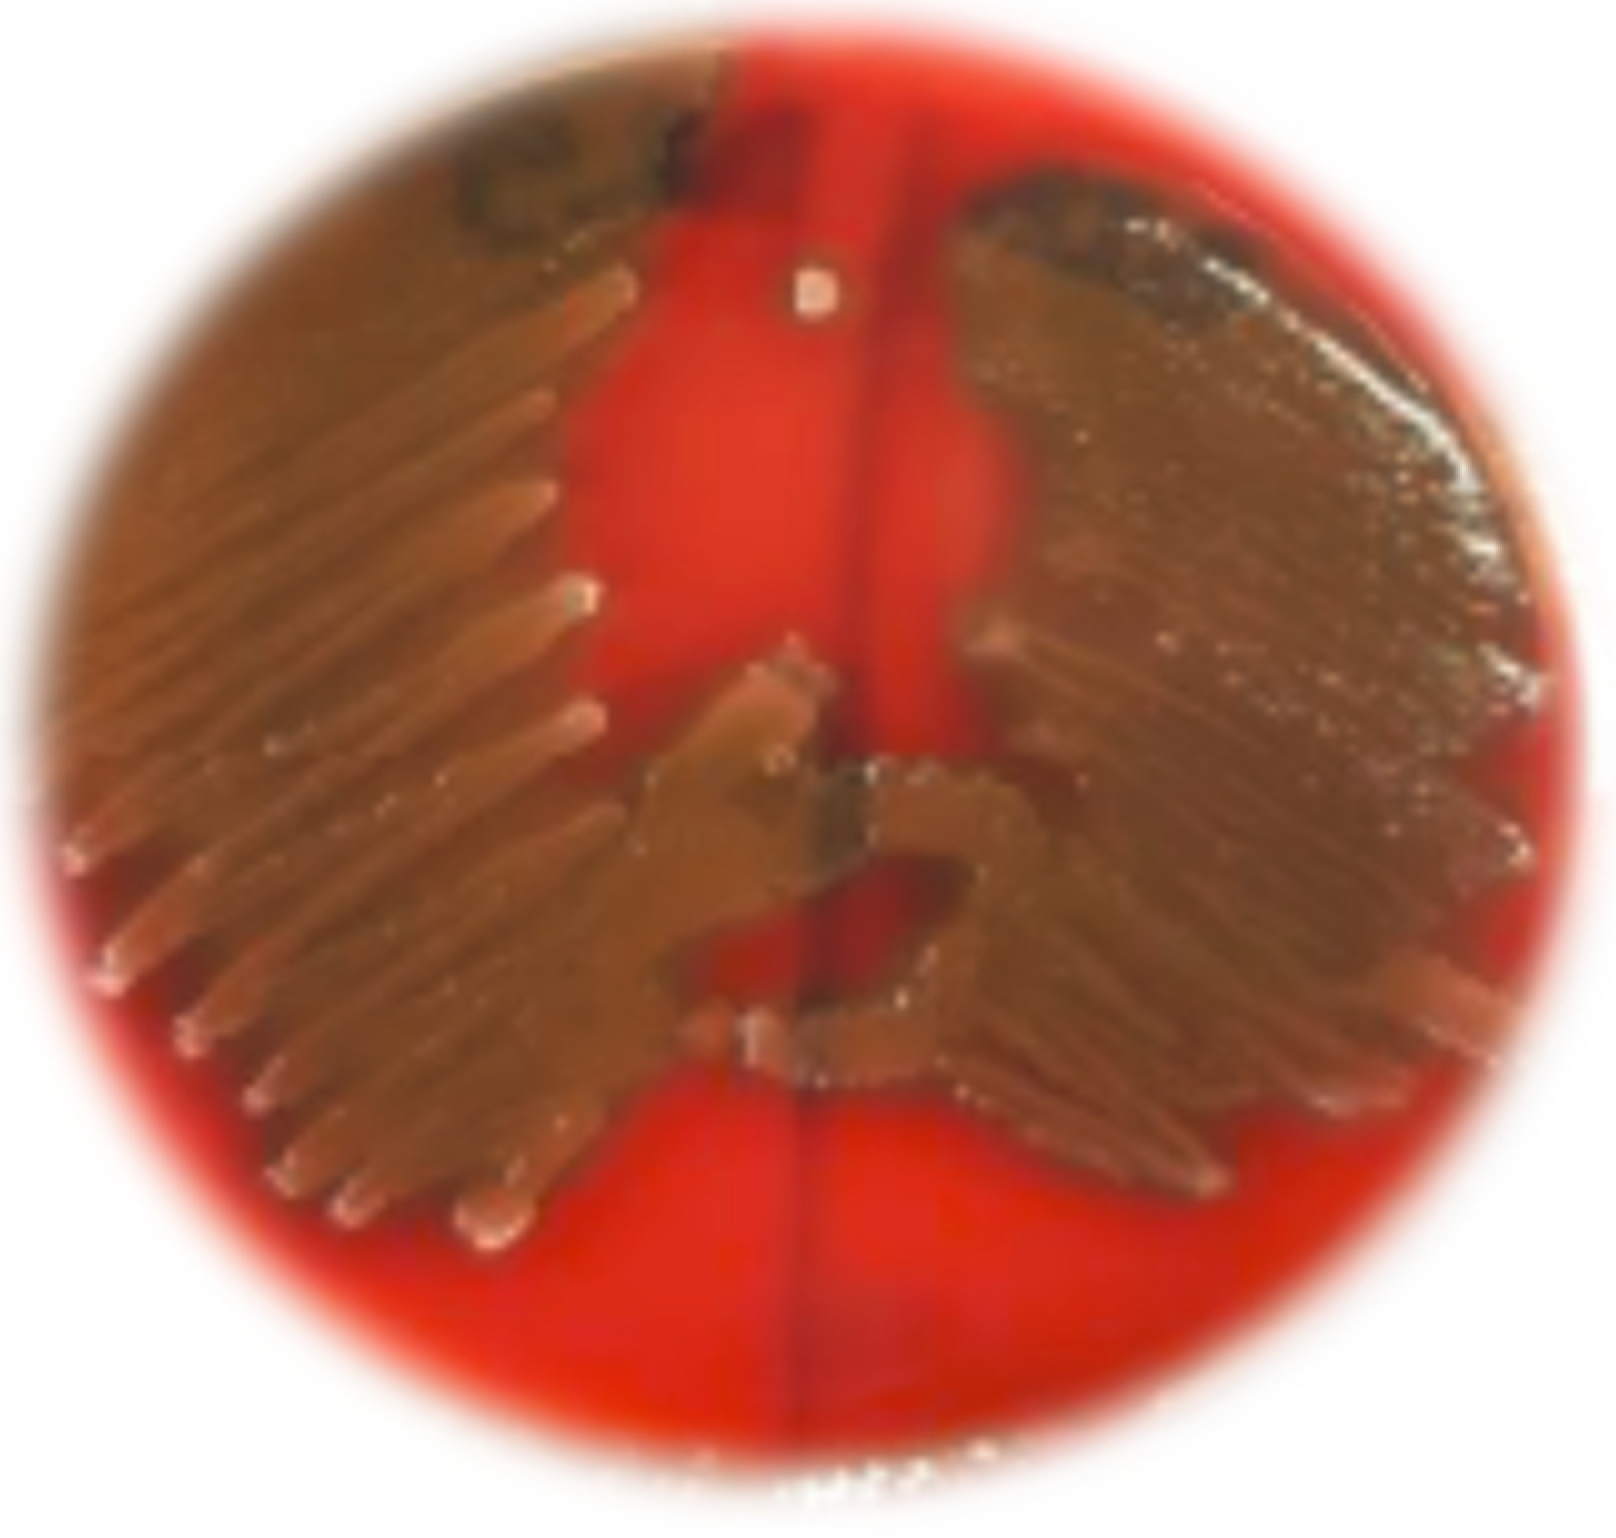
Blsf 40 00030 g003

Assessment of Safety and Probiotic Properties of Soil Bacillus from Mount Karadzica †
Abstract
1. Introduction
2. Materials and Methods
2.1. Sampling, Bacterial Isolation, and Identification
2.2. In Vitro Assessment of Probiotic Properties
2.2.1. Survival Under Gastric Juice Conditions and Bile Salts
2.2.2. Optimum Temperature and Growth Tolerance in Presence of Sodium Chloride
2.2.3. Arginine Hydrolysis and Catalase Tests
2.3. Safety Assessment
2.3.1. Antibiotic Susceptibility
2.3.2. Hemolysis Test
3. Results
3.1. Sampling, Bacterial Isolation, and Identification
3.2. In Vitro Assessment of Probiotic Properties
3.2.1. Survival Under Gastric Juice Conditions and Bile Salts
3.2.2. Optimum Temperature and Growth Tolerance in Presence of Sodium Chloride
3.2.3. Arginine Hydrolysis and Catalase Tests
3.3. Safety Assessment
3.3.1. Antibiotic Susceptibility
3.3.2. Hemolysis Test
4. Discussion
5. Conclusions
Author Contributions
Funding
Institutional Review Board Statement
Informed Consent Statement
Data Availability Statement
Conflicts of Interest
References
- Thi Lan Anh, H.; Thi Thanh Hue, L.; Hai Linh, B.N.; Tuan Dung, N.H.; Duong Minh, D.; Thi Le Quyen, T.; Trung, T.T. In vitro safety evaluation of Bacillus subtilis species complex isolated from Vietnam and their additional beneficial properties. Vietnam J. Biotechnol. 2022, 20, 727–740. [Google Scholar] [CrossRef]
- Tenea, G.N.; Gonzalez, G.L.; Moreno, J.L. Probiotic Characteristics and Antimicrobial Potential of a Native Bacillus subtilis Strain Fa17.2 Rescued from Wild Bromelia sp. Flowers. Microorganisms 2022, 10, 860. [Google Scholar] [CrossRef] [PubMed]
- Su, Y.; Liu, C.; Fang, H.; Zhang, D. Bacillus subtilis: A universal cell factory for industry, agriculture, biomaterials and medicine. Microb. Cell Factories 2020, 19, 173. [Google Scholar] [CrossRef] [PubMed]
- Souza, V.L.; Lopes, N.M.; Zacaroni, O.F.; Silveira, V.A.; Pereira, R.A.N.; Freitas, J.A.; Almeida, R.; Salvati, G.G.S.; Pereira, M.N. Lactation performance and diet digestibility of dairy cows in response to the supplementation of Bacillus subtilis spores. Livest. Sci. 2017, 200, 35–39. [Google Scholar] [CrossRef]
- Golnari, M.; Bahrami, N.; Milanian, Z. Isolation and characterization of novel Bacillus strains with superior probiotic potential: Comparative analysis and safety evaluation. Sci. Rep. 2024, 14, 1457. [Google Scholar] [CrossRef] [PubMed]
- Ciurescu, G.; Dumitru, M.; Gheorghe, A.; Untea, A.E.; Drăghici, R. Effect of Bacillus subtilis on growth performance, bone mineralization, and bacterial population of broilers fed with different protein sources. Poult. Sci. 2020, 99, 5960–5971. [Google Scholar] [CrossRef] [PubMed]
- Park, K.M.; Yoon, S.-G.; Choi, T.-H.; Kim, H.J.; Park, K.J.; Koo, M. The Bactericidal Effect of a Combination of Food-Grade Compounds and their Application as Alternative Antibacterial Agents for Food Contact Surfaces. Foods 2020, 9, 59. [Google Scholar] [CrossRef] [PubMed]
- Kimelman, H.; Shemesh, M. Probiotic Bifunctionality of Bacillus subtilis—Rescuing Lactic Acid Bacteria from Desiccation and Antagonizing Pathogenic Staphylococcus aureus. Microorganisms 2019, 7, 407. [Google Scholar] [CrossRef] [PubMed]
- Brutscher, L.M.; Borgmeier, C.; Garvey, S.M.; Spears, J.L. Preclinical Safety Assessment of Bacillus subtilis BS50 for Probiotic and Food Applications. Microorganisms 2022, 10, 1038. [Google Scholar] [CrossRef] [PubMed]
- Atanasova-Pancevska, N.; Kungulovski, D.; Petrova, E.U.; Radmanovik, N.; Boskovski, O.; Frcovski, E.; Premcevski, H.; Kostandinovska, S. The Influence of Different Climatic Types on the Number of Bacillus spp. Isolated from Soil in North Macedonia. J. Agric. Plant Sci. 2023, 21, 31–40. [Google Scholar] [CrossRef]
- Nguyen, T.D.; Kang, J.H.; Lee, M.S. Characterization of Lactobacillus plantarum PH04, a Potential Probiotic Bacterium with Cholesterol-lowering Effects. Int. J. Food Microbiol. 2007, 113, 358–361. [Google Scholar] [CrossRef] [PubMed]
- Gilliand, S.E.; Staley, T.E.; Bush, L.J. Importance of bile tolerance of Lactobacillus acidophilus used as a dietary adjunct. J. Dairy Sci. 1984, 67, 3045–3051. [Google Scholar] [CrossRef] [PubMed]
- Kostandinovska, S.; Kungulovski, D.; Atanasova-Pancevska, N. Potential Probiotic Bacillus Strains Isolated from Contaminated Soil in North Macedonia: Salmonella Growth Inhibition. Biol. Life Sci. Forum 2024, 31, 17. [Google Scholar] [CrossRef]
- Lee, N.-K.; Han, K.J.; Son, S.-H.; Eom, S.J.; Lee, S.-K.; Paik, H.-D. Multifunctional Effect of Probiotic Lactococcus lactis KC24 Isolated from Kimchi. LWT Food Sci. Technol. 2015, 62, 1036–1041. [Google Scholar] [CrossRef]
- Zulkhairi Amin, F.A.; Sabri, S.; Ismail, M.; Chan, K.W.; Ismail, N.; Mohd Esa, N.; Mohd Lila, M.A.; Zawawi, N. Probiotic Properties of Bacillus Strains Isolated from Stingless Bee (Heterotrigona itama) Honey Collected across Malaysia. Int. J. Environ. Res. Public Health 2020, 17, 278. [Google Scholar] [CrossRef] [PubMed]
- Wang, Y.; Zhang, H.; Zhang, L.; Liu, W.; Zhang, Y.; Zhang, X.; Sun, T. In vitro Assessment of Probiotic Properties of Bacillus Isolated from Naturally Fermented Congee from Inner Mongolia of China. World J. Microbiol. Biotechnol. 2010, 26, 1369–1377. [Google Scholar] [CrossRef]
- Lee, A.; Cheng, K.-C.; Liu, J.-R. Isolation and Characterization of a Bacillus amyloliquefaciens strain with Zearalenone Removal Ability and its Probiotic Potential. PLoS ONE 2017, 12, e0182220. [Google Scholar] [CrossRef] [PubMed]
- Jeon, H.-L.; Lee, N.-K.; Yang, S.-J.; Kim, W.-S.; Paik, H.-D. Probiotic Characterization of Bacillus subtilis P223 Isolated from Kimchi. Food Sci. Biotechnol. 2017, 26, 1641–1648. [Google Scholar] [CrossRef] [PubMed]
- Deng, F.; Chen, Y.; Sun, T.; Wu, Y.; Su, Y.; Liu, C.; Zhou, J.; Deng, Y.; Wen, J. Antimicrobial Resistance, Virulence Characteristics and Genotypes of Bacillus spp. from Probiotic Products of Diverse Origins. Food Res. Int. 2021, 139, 109949. [Google Scholar] [CrossRef] [PubMed]
- Yelin, I.; Flett, K.B.; Merakou, C.; Mehrotra, P.; Stam, J.; Snesrud, E.; Hinkle, M.; Lesho, E.; McGann, P.; McAdam, A.J.; et al. Genomic and Epidemiological Evidence of Bacterial Transmission from Probiotic Capsule to Blood in ICU Patients. Nat. Med. 2019, 25, 1728–1732. [Google Scholar] [CrossRef] [PubMed]

| Isolates | Optimal Temperature | Turbidity (FAU) |
|---|---|---|
| B25 | 44 °C | 250 |
| B26 | 30 °C | 150 |
| B27 | 30 °C | 85 |
| B28 | 44 °C | 178 |
| B29 | 30 °C | 206 |
| B30 | 37 °C | 150 |
| B85 | 30 °C | 164 |
Disclaimer/Publisher’s Note: The statements, opinions and data contained in all publications are solely those of the individual author(s) and contributor(s) and not of MDPI and/or the editor(s). MDPI and/or the editor(s) disclaim responsibility for any injury to people or property resulting from any ideas, methods, instructions or products referred to in the content. |
© 2025 by the authors. Licensee MDPI, Basel, Switzerland. This article is an open access article distributed under the terms and conditions of the Creative Commons Attribution (CC BY) license (https://creativecommons.org/licenses/by/4.0/).
Share and Cite
Kostandinovska, S.; Kungulovski, D.; Atanasova-Pancevska, N. Assessment of Safety and Probiotic Properties of Soil Bacillus from Mount Karadzica. Biol. Life Sci. Forum 2024, 40, 30. https://doi.org/10.3390/blsf2024040030
Kostandinovska S, Kungulovski D, Atanasova-Pancevska N. Assessment of Safety and Probiotic Properties of Soil Bacillus from Mount Karadzica. Biology and Life Sciences Forum. 2024; 40(1):30. https://doi.org/10.3390/blsf2024040030
Chicago/Turabian StyleKostandinovska, Sofija, Dzoko Kungulovski, and Natalija Atanasova-Pancevska. 2024. "Assessment of Safety and Probiotic Properties of Soil Bacillus from Mount Karadzica" Biology and Life Sciences Forum 40, no. 1: 30. https://doi.org/10.3390/blsf2024040030
APA StyleKostandinovska, S., Kungulovski, D., & Atanasova-Pancevska, N. (2024). Assessment of Safety and Probiotic Properties of Soil Bacillus from Mount Karadzica. Biology and Life Sciences Forum, 40(1), 30. https://doi.org/10.3390/blsf2024040030

